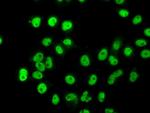
HNRNPF Antibody in Immunocytochemistry (ICC/IF)

Search
OriGene
HNRNPF Monoclonal Antibody (OTI5F5), TrueMAB™
{{$productOrderCtrl.translations['antibody.pdp.commerceCard.promotion.promotions']}}
{{$productOrderCtrl.translations['antibody.pdp.commerceCard.promotion.viewpromo']}}
{{$productOrderCtrl.translations['antibody.pdp.commerceCard.promotion.promocode']}}: {{promo.promoCode}} {{promo.promoTitle}} {{promo.promoDescription}}. {{$productOrderCtrl.translations['antibody.pdp.commerceCard.promotion.learnmore']}}
产品信息
TA500804
种属反应
宿主/亚型
分类
类型
克隆号
抗原
偶联物
形式
浓度
纯化类型
保存液
内含物
保存条件
运输条件
靶标信息
This gene belongs to the subfamily of ubiquitously expressed heterogeneous nuclear ribonucleoproteins. The hnRNPs are RNA binding proteins that complex with heterogeneous nuclear RNA. These proteins are associated with pre-mRNAs in the nucleus and regulate alternative splicing, polyadenylation, and other aspects of mRNA metabolism and transport. While all of the hnRNPs are present in the nucleus, some seem to shuttle between the nucleus and the cytoplasm. The hnRNP proteins have distinct nucleic acid binding properties. The protein encoded by this gene has three repeats of quasi-RRM domains that bind to RNAs which have guanosine-rich sequences. This protein is very similar to the family member hnRPH. Multiple alternatively spliced variants, encoding the same protein, have been identified.
仅用于科研。不用于诊断过程。未经明确授权不得转售。
篇参考文献 (0)
生物信息学
蛋白别名: Heterogeneous nuclear ribonucleoprotein F; hnRNP F; HnRNP F protein; hnRNP H; HNRNPH1; mcs94 1; Nucleolin-like protein mcs94-1; ROF
基因别名: HNRNPF; HNRPF; mcs94-1; OK/SW-cl.23
UniProt ID: (Human) P52597
Entrez Gene ID: (Human) 3185